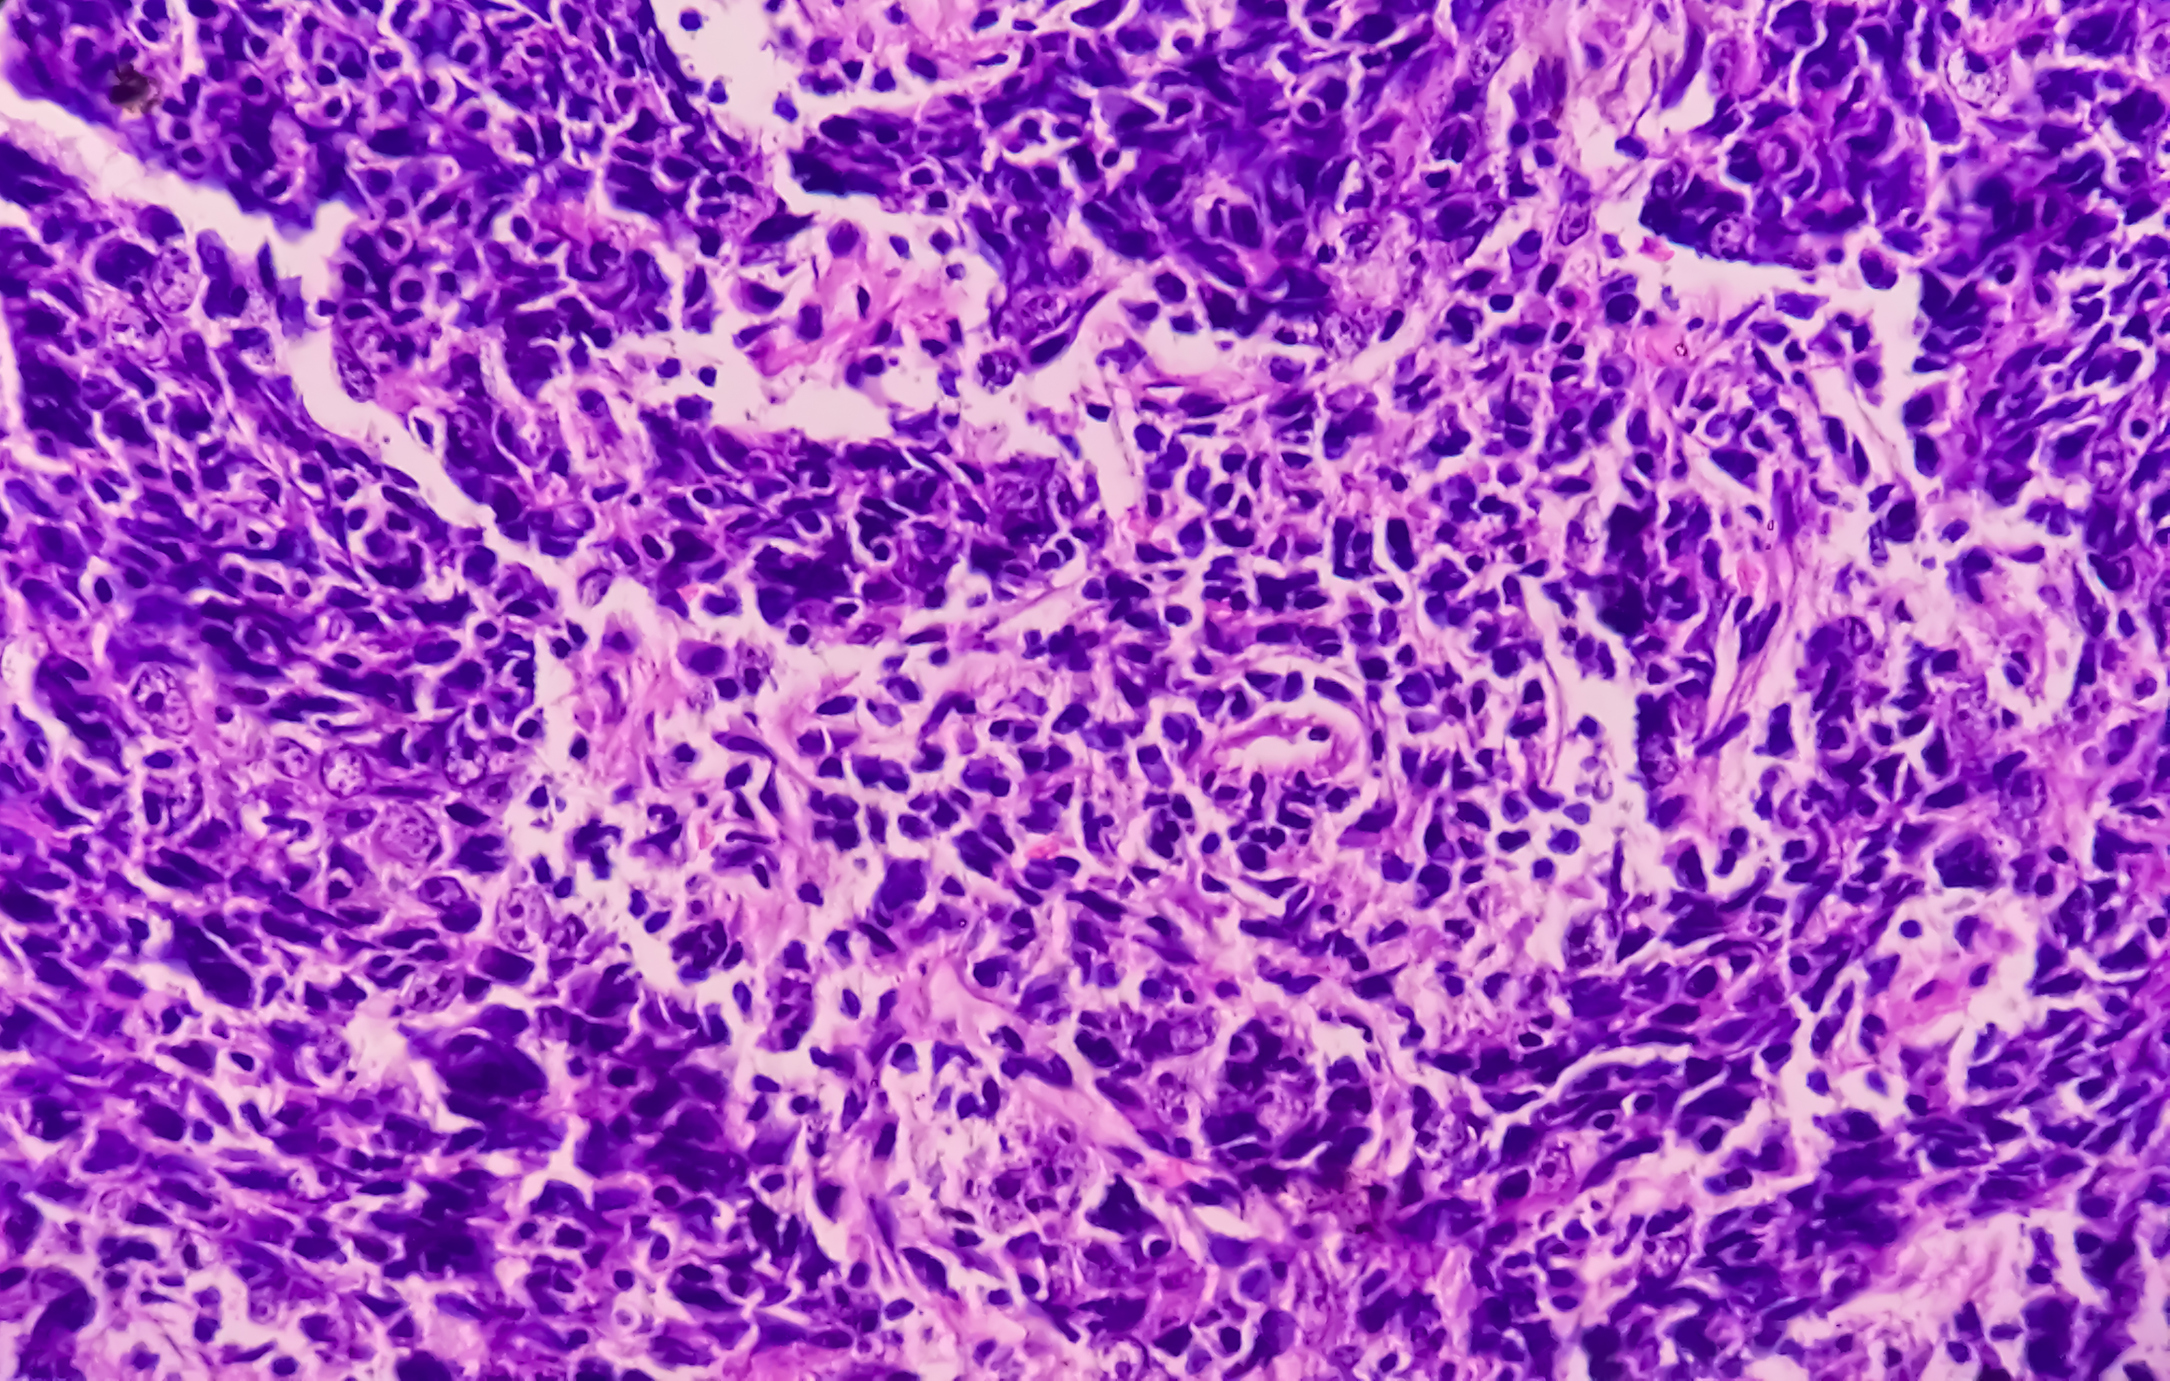

Nasopharyngeal Cancer
Learn about nasopharyngeal cancer
Cancers of the Nasopharynx occur in the upper part of the throat, where the nasal passages and auditory tubes join just behind the soft palate in the mouth. Benign tumours in the nasopharyngeal cavity are quite rare, and more prevalent in young adults or children.
Most cancerous tumours in the nasopharanyx start from the epithelial cells – skin-like cells that line the surface of the area – and are classified as squamous cell carcinomas.
Other cancers that may arise in the nasopharnyx are Lymphomas, which are cancers of the immune system. Also, cancers of the salivary glands may occur in the nasopharynx, but they are more common in either the nasal cavity or the mouth.
Many people with Nasopharyngeal Cancerpresent with a lump (or more than one lump) in the neck when they first visit their GP. These lumps are rarely painful, however they have been caused because the cancer has spread to the lymph nodes.
Other symptoms of Nasopharyngeal Cancer are:
- Hearing loss, ringing or fullness in the ear
- Ear infections (more common in children)
- Blockages in the nasal passage
- Nosebleeds
- Headaches
- Blurred or double vision
- Pain in the facial area
- Difficulty opening the mouth
These symptoms are common across a range of health conditions, so please consult your GP for a thorough examination.
Diagnosing Nasopharyngeal Cancer
The nasopharynx is a difficult part of the body to access, and so specialists will use a range of techniques to diagnose the cancer. In many cases, a fibre-optic scope can be used to look directly at the affected area. It is inserted through the nose and will help the specialist inspect the nasopharynx.
Even if the cancer is not evident through this physical examination, the fibre-optic scope will assist your doctor to take a sample of the cells at this point, for further examination under a microscope.
If the patient presents with a suspicious lump in their neck, a fine needle biopsy can be used to withdraw a few drops of fluid for assessment. This method can help determine if the lump is a result of infection, a cancer that has started in the lymph nodes, or a cancer that has spread from elsewhere.
Nasopharyngeal Cancer Treatment
Imaging tests such as x-ray, MRI, PET, etc may be used to support the diagnosis and further assess the extent of the tumour. Depending on how far the cancer has spread, any combination of surgery, radiation therapy, or chemotherapy may be advised. For the majority of nasopharyngeal cancers, and due to the difficult location of the cancer, a combination of radiation and chemo will be used.
Surgery is more often an option to remove the cancer when it has spread to the lymph nodes in the neck.
In most parts of the world, Nasopharyngeal Cancer is quite rare. However, it is more common in certain parts of Asia (particularly Southern China), North Africa and far North Canada. It is far more common in men compared with women, and while the risk of nasopharyngeal cancer will increase with age, it affects children as well as adults.
Nasopharyngeal Cancer has been linked to some viruses, including the Epstein-Barr, and the human papillomavirus, however the causal role of these viruses is complicated. The incidence of these viruses is more common than the incidence of nasopharyngeal cancer, and so it is expected that other environmental or genetic factors will affect the development (or not) of cancer within the pharynx.
Research is ongoing into inherited, dietary, viral or other environmental influences.

